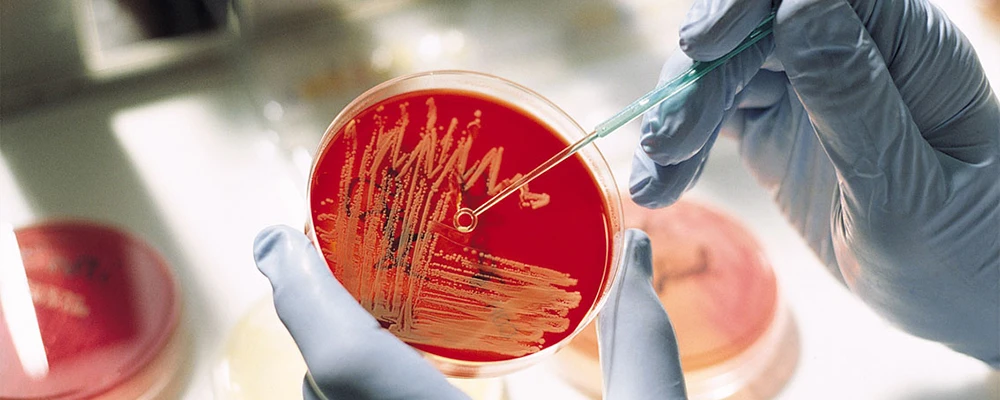

43092
43092 43092
43092Микробиом кожи – популярная тема. Практически каждую неделю появляются новые данные о том, что те или иные бактерии повинны в развитии дерматологических болезней, таких как акне, розацеа, псориаз и т.д.
А раз враг обнаружен, то его, понятно, следует тут же обезвредить, разработав инновационные косметические формулы и выпустив их на рынок.
Складывается впечатление, что сегодня поверхность кожи исхожена человеком вдоль и поперек, как поверхность Луны.
Почему же мы решили зайти на эту изведанную территорию?
Мы постоянно отслеживаем мировые тенденции в эстетической медицине и дерматологии и в последнее время не могли не отметить появляющиеся controversies вокруг темы микробиома.
В этой статье мы попытаемся разобраться, так ли они обоснованны, и где в этой теме кончается наука и начинается маркетинг?
Но сначала вернемся ненадолго в университет.
По данным американских микробиологов (Grice 2011), на коже находится 1,8 м2 разнообразных мест обитания микроорганизмов, включая бактерии, грибы, вирусы, клещи.
Микрофлора делится на постоянную – резидентную (около 90 % микробов), факультативную (условно-патогенную) – около 9,5 % и случайную (транзиторную) – 0,5 %.
Согласно доктору медицинских наук Виктору Бондаренко, заведующему лабораторией генетики вирулентности бактерий Института эпидемиологии и микробиологии им. Н. Ф. Гамалеи РАМН, около 20 % микроорганизмов от общего числа обитает в полости рта (более 200 видов), 18–20 % приходится на кожные покровы, 15–16 % — на глотку, 2–4 % – на урогенитальный тракт у мужчин и примерно 10 % – на вагинальный биотоп у женщин, а больше всего микроорганизмов (до 40 %) – в желудочно-кишечном тракте (Бондаренко 2007).
Микробиом кожи определяется такими факторами, как pH, температура, влажность, уровень выработки кожного сала, окислительный стресс, диета, инфекции. Кожа обладает высокой обновляемостью клеток, поскольку она постоянно противостоит воздействию внешних факторов.
Микробиом кожи меняется от человека к человеку. Уникальный профиль микробиоты человека задается в зависимости от «экониши», на него также влияет количество света и влажности/сухости, число волосяных фолликулов, пол и возраст (Krajewska-Włodarczyk 2017).
Некоторые распространенные полезные и патогенные бактерии приведены в таблице ниже, а также в ранее опубликованных на портале статьях.

Таблица 1. Кожный микробиом
| Нормальная микрофлора | Патогенная микрофлора |
| Streptococcus viridans (стрептококк зеленящий) – нормальные обитатели полости рта, глотки, носа | Staphylococcus aureus (золотистый стафилококк) |
| Staphylococcus saprophyticus (стафилококк сапрофитный) – самый мирный из стафилококков, основное его место обитания – это стенка мочевого пузыря и кожа вблизи гениталий, поэтому нетрудно догадаться, что он является возбудителем цистита, которому больше подвержены женщины | Streptococcus pyogenes (стрептококк пиогенный, он же бета-гемолитический стрептококк группы А) – дает осложнения в виде ревматизма, поражая почки, сосуды мозга, сердце, суставы |
| Staphylococcus epidermidis (стафилококк эпидермальный) – обитает в различных областях слизистых и кожных покровов. Эпидермис – поверхностный слой кожи, отсюда и название | Streptococcus pneumoniae (пневмококк) – возбудитель пневмонии и менингита |
| Staphylococcus haemolyticus (стафилококк гемолитический) | Pseudomonas aeruginosa (синегнойная палочка) |
| Грибы рода Candida | Klebsiella pneumoniae, ozaenae, rhinoscleromatis (клебсиеллы пневмонии, озены, риносклеромы) |
| Непатогенные виды бацилл, коринебактерии и др. | Yersinia enterocolitica, pseudotuberculosis (иерсинии энтероколита и превдотуберкулеза) |
Известно, что сухие участки кожи на предплечьях, ягодицах и кистях активно заселены бактериями вида Actinobacteria, Proteobacteria, Firmicutes и Bacteriodetes. Удивительной особенностью микробиоты этих зон является обилие граммотрицательных организмов. Когда-то считалось, что они колонизируют кожу редко. Интересно, что на этих участках разнообразие бактерий больше, чем в кишечнике или полости рта одного и того же человека. Кроме того, микроорганизмы «привязаны» к текущему участку тела. И, пересаженные из одной среды обитания в другую, например, с языка на лоб, не способны колонизировать новую территорию или изменить существующее в этой области микробное сообщество (Costello et al. 2009).
Как этому невидимому и густонаселенному миру удается относительно спокойно и мирно существовать друг с другом на таком ограниченном участке, как наша кожа?
Ответ кроется в гомеостазе.
Чтобы эффективно выполнять свою защитную функцию (физического и иммунного барьера при стрессах, внешних вмешательствах или инфекциях), кожа полагается на механизмы непрерывного удаления мертвых клеток.
Это происходит в результате гомеостаза, когда на коже поддерживается баланс между иммунорегуляцией и толерантностью к внешней среде. Если это равновесие нарушается, иммунная система может нанести удар и начать патогенез (Belkaid 2014; Sil et al. 2018).
Многие механизмы кожного гомеостаза до сих пор не до конца понятны и изучены, а то, что известно, подробно изложено в учебниках. Здесь, чтобы не цитировать страницы, мы опишем лишь некоторые важные открытия на пути к этому пониманию.
Если вы не хотите утомлять себя обилием терминов, то можете без вреда пропустить этот раздел.
Рецептор ароматических углеводородов AhR – это белок, который относится к лиганд-зависимым транскрипционным факторам и осуществляет регуляцию ферментов, способствующих метаболизму ксенобиотиков.
Он опосредует многочисленные биологические и токсикологические эффекты, индуцируя транскрипцию различных чувствительных к AhR генов.
Японские ученые исследовали роль этого белка и пришли к выводу, что он оказывает ряд функциональных воздействий на гомеостаз кожи (Furue et al. 2014).
Они установили следующее:
И это далеко не полный список реакций, в которых принимает участие этот белок, во многом его действие остается загадочным.

Немецкие ученые занимались изучением нарушений в передаче сигналов Wnt и его роли в поддержании барьерной функции кожи для ее правильного физического, биохимического и иммунологического функционирования (Augustin 2015).
Они установили, что кожа является сложным динамическим органом с высоким клеточным обменом, при котором стволовые клетки обеспечивают постоянное обновление кожи. Сигнальный путь Wnt контролирует рост стволовых клеток и участвует в обновлении различных тканей. Нарушение передачи сигналов Wnt в коже вызывает такие нарушения, как алопеция, хронические воспалительные заболевания кожи или рак.
Много исследований было сосредоточено на клеточных и молекулярных механизмах, которые регулируют биологию кожи. Факторы транскрипции являются ключевыми молекулами, которые настраивают экспрессию генов и способствуют или подавляют транскрипцию гена. И эпидермис является ключевым источником транскрипционных факторов, которые регулируют многие функции эпидермальных клеток, такие как пролиферация, дифференцировка, апоптоз и миграция.
В одном из недавних исследований было установлено, что активация эпидермальных факторов транскрипции вызывает изменения в дерме кожи (Bukowska et al. 2018).
Транскрипционный фактор Foxn1 играет особую роль в биологии кожи. Регуляторная функция Foxn1 связана с физиологическими (развитие и гомеостаз) и патологическими (заживление ран) изменениями. В частности, Foxn1 участвует в способности кожи регулировать образование рубцовой ткани, что может быть перспективно в регенеративной медицине.
В развитии микробиома и регуляции бактерий, которые колонизируют поверхность кожи, решающее значение имеет иммунная система, а получаемые от микробов сигналы постоянно формируют и устанавливают ответ иммунных реакций.
Канадские ученые установили, что иммунный ответ второго типа лежит в основе развития атопии и аллергии. Микробы модулируют иммунные ответы типа 2 через воздействие на цитокины типа 2, дендритные клетки и регуляторные Т-клетки. Микробная колонизация в кишечнике, легких и коже в ранний период иммунного развития, по-видимому, имеет особое значение для развития толерантности и регуляции иммунных ответов, которые позднее могут быть связаны с аллергией (McCoy et al. 2018).
Даже вышеприведенных немногочисленных данных достаточно, чтобы прийти к выводу о том, что микромир тонок, неоднозначен и непостоянен, а протекающая в этом мире бурная активность, взаимодействия и регуляция еще не до конца понятны.
Хотя человек и изучил кожу, установил количественное соотношение микрофлоры, классифицировал и присвоил бактериям романтичные названия (вспомним глобальный проект «Микробиом человека», начатый в 2008 году), но нам так и не удалось установить причинно-следственные связи между этими процессами.
Однако набирают популярность мнения, что виной кожных болезней являются нарушения в микробиоме, иначе дисбаланс микроорганизмов.
Но так ли это на самом деле? Корректно ли делить бактерии на «вредных» и «полезных»?
Мы привели лишь крошечную часть данных. Исследования также показывают, что дисбаланс микрооорганизмов может лежать в корне и таких заболеваний, как синдром Крона, колиты и синдром раздраженного кишечника, аутоиммунные заболевания, склероз или диабет I типа (Campbell 2014).
Конечно, при таких данных есть соблазн «свалить» всю вину за болезнь на бактерии.
Группа американских ученых (Wallen-Russell et al. 2017) высказала обоснованные сомнения новомодным течениям.
Они отметили следующее:
Более того, ученые пошли еще дальше.
Они заявили, что многие исследования причин возникновения кожных болезней были сосредоточены на поиске связей между конкретными типами микробов, обитающими на коже, и специфическими кожными заболеваниями (Wallen-Russell et al. 2017).
Однако (sic!) на данный момент недостаточно доказательств того, что здоровая или нездоровая кожа определяется наличием специфических доминирующих типов микробиома (Findley et al. 2014).
Например, рассмотрим акне.
На протяжении десятилетий изучалась роль Propionibacterium acnes в патогенезе болезни, но роль этой бактерии все еще неясна, но установлено, что этот микроорганизм является главным симбионтом нормальной флоры кожи, P. acnes использует липиды кожи для получения короткоцепочечных жирных кислот, которые могут аналогичным образом предотвратить микробиологические угрозы (Grice et al. 2011; Dessinioti et al. 2010).
Возникает закономерный вопрос: к какой категории тогда следует относить P. Acnes?
Записывать ли ее во врага и кидать все силы на ее истребление?
Или сделать другом?
Способность кожи противостоять инфекциям и болезням является очень сложным многофакторным процессом.
Это комбинация большого количества систем, которые должны работать в синергизме (Grice et al. 2008; Cogen et al. 2009). К ним относятся физический барьер, поверхностный рН хозяина и «активный синтез» генетически кодируемых молекул в его организме.
Неграмотно проводить различия между «полезными» и «вредными» микроорганизмами. Можно только опираться на способность самой кожи противостоять болезням и инфекциям, а не пытаться объяснять это «сложным внутренним миром» самих микробов, навешивая на них субъективные ярлыки «отрицательных» или «положительных» героев.
Кроме того, нельзя забывать о связи кожи с иммунной системой.
Микробы на коже могут влиять на поведение иммунных клеток. Недавние испытания показали, что Staphylococcus epidermidis помогает иммунной системе контролировать инфекции, изменяя функцию Т-клеток (ключевой компонент адаптивного иммунного ответа организма) для повышения иммунитета хозяина.
Исследования обнаружили, что различные микробы сообща влияют на составляющие иммунной системы, и то, как они общаются с иммунной системой, очень специфично для каждого микроба (Wallen-Russell et al. 2017).
Многие из кожных микроорганизмов являются безвредными и в некоторых случаях обеспечивают жизненно важные функции, которые человеческий геном не развил. Симбиотические микроорганизмы занимают широкий спектр кожных ниш и защищают от вторжения более патогенных или вредных организмов. Эти микроорганизмы могут также влиять на миллиарды Т-клеток, которые с их помощью учатся противостоять патогенам.
И вся эта система должна находиться в тонком балансе не только между собой, но еще и «дружить» с организмом-хозяином.
Американцы показали, что разнообразие микробов – это гарантия стабильности и равновесия в организме (Wallen-Russell et al. 2017).
Вывод: чем разнообразнее микробиом, тем лучше здоровье.
Стоит ли однозначно полагаться на популярные мнения о том, что микробиотические продукты различной направленности – это средство Макропулоса?
Могут ли эти препараты нарушить спокойствие в микромире?
На первый взгляд, нет.
Но, вот, казалось бы, популярный и безобидный витамин B12, который многие пациенты принимают в качестве биологически активной добавки.
Недавно канадские врачи (Kang et al. 2015) выяснили, что биосинтез этого витамина в присутствии бактерий Propionibacterium acnes значительно снижался у пациентов с угревой болезнью. Они предположили, что человек, принимающий витамин B12, модулирует деятельность микробиоты кожи и способствует патогенезу акне.
Чтобы проверить эту гипотезу, канадцы проанализировали микробиоту кожи у здоровых людей, и дополнили ее витамином B12.
Они обнаружили, что добавка витамина подавляет экспрессию генов биосинтеза витамина B12 у P. acnes и изменяет транскриптомы микробиоты кожи.
В результате у одного из десяти испытуемых появилось акне через неделю после приема витамина.
Кроме того, проанализировав молекулярный механизм, ученые обнаружили, что добавка витамина B12 в культуры P. acnes способствовала производству порфиринов, которые, как уже известно, провоцируют воспалительный процесс.
Это новое свидетельство о роли внешнего провоцирующего фактора, подрывающего тонкий баланс.
А сколько еще предстоит выяснить?
Схожие вопросы возникают и в теме популярных, особенно в России, добавок с пре- и пробиотиками.
Пребиотики не содержат живых микроорганизмов, но стимулируют размножение «хорошей» микрофлоры за счет создания питательной среды.
Есть еще группа синбиотиков, продуктов, совмещающих пробиотики и пребиотики.
Идея использования пробиотиков для восстановления флоры кишечника постулируется очень давно (см., например, Rowland et al. 2009), и проблема с внутренней средой организма заключается в том, что она недоступна и изолирована от внешней среды и ее сложно изучать и поэтому контролировать (Grönlund et al. 1999).
С кожей все должно быть проще – она видна невооруженным глазом, ежедневно подвергается внешнему воздействию и не имеет проблемы доступа к микробиому.
Но опять появляется «но».
Американцы установили, что на кожу влияет окружающая среда, которая провоцирует проблемы, и поэтому бессмысленно использовать «пробиотические» средства, если в окружающей среде присутствует что-то, что сразу же нивелирует эффект (см. Wallen-Russell et al. 2017).
Как только действие пробиотиков заканчивается, кожа сразу же возвращается в привычное состояние.
Кроме того, есть и сложности при производстве пробиотиков.
Мы обратились к эксперту – косметическому химику Юлии Гагариной – и попросили ее рассказать, какие особенности бывают при использовании пробиотических продуктов и когда их уместно применять.
Для использования пробиотиков в косметике есть определенные сложности – бифидо-, ацидо- и лактобактерии не способны образовывать споры и легко разрушаются.
При выборе пробиотического препарата возникает несколько проблемных вопросов.
Первый – выживаемость, так как пробиотическими свойствами обладают только живые микробы. Более того, целым рядом работ было показано, что минимально достаточной дозой, способной осуществлять значимое действие, может считаться доза не менее 107 КОЕ (Saavedra 2001).
Выживаемость бактерий зависит от технологии производства и условий хранения препарата. Например, добавление бифидобактерий в кефир не гарантирует их сохранности и способности к размножению; жизнеспособность микрофлоры как в жидких, так и в простых сухих формах препаратов может быть утрачена ранее официального срока. Для большинства пробиотиков, особенно для жидких лекарственных форм, требуются особые условия хранения, например, температура.
Следует учитывать разрушительное действие желудочного сока на незащищенную флору. Доказано, что лишь небольшое число штаммов лактобактерий (L. reuteri, L. plantarum NCIB8826, S. boulardii, L. acidophilus, L. casei Shirota) и бифидобактерий обладает кислотоустойчивостью. Большинство микробов погибает в желудке.
По данным Анатолия Безкоровайны (Bezkorovainy 2001), лишь 20–40 % селективных штаммов выживает в желудке.
Д. Почарт (Pochart et al. 1992) продемонстрировал, что из 108 микр. тел лактобактерий, принятых в кислотоустойчивой капсуле, в кишечнике обнаруживается 107, после приема такого же количества в йогурте – 104 микр. тел, а после приема той же дозы в открытом виде (порошок) микробы в кишечнике не обнаруживаются вовсе. Поэтому предпочтительны пробиотики, заключенные в кислотоустойчивую капсулу.
Впрочем, после того как микробиологическое равновесие в кишечнике будет восстановлено, прием различных кисломолочных продуктов нужен и важен!
По данным публикаций, внутренний прием различных видов пробиотиков эффективен для решения ряда проблем кожи (табл. 2).
Таблица 2. Штаммы пробиотиков, которые исследовались относительно положительного влияния при лечении различных видов заболеваний
| Виды пробиотиков | Штамм | ЖКТ | Экзема | Аллергии | Акне | Иммуномодуляция |
| Bifidobacterium animalis | х | х | х | |||
| Bifidobacterium lactis | х | х | х | |||
| Bifidobacterium longum | х | х | ||||
| Lactobacillus acidophilus | х | х | х | |||
| Lactobacillus casei | Shirota | х | х | х | ||
| Lactobacillus plantarum | х | х | х | |||
| Lactobacillus gasseri | х | |||||
| Lactobacillus rhamnosus | GG | х | х | х | х | |
| Lactococcus lactis | х |
Бактерии используют очень широко и в продуктах по уходу за кожей. В средствах для волос они работают как укрепляющие и стимулирующие рост. Также на их основе можно делать инновационные консерванты («мертвые бактерии (лизаты) – убивают живые бактерии»).
Вот примеры:
Мы написали эту статью, чтобы показать, что все классификации и споры о полезных и вредных бактериях условны.
Когда в 2008 году Национальные институты здравоохранения США затеяли крупный проект Human Microbiome Project, подобный столь же масштабному проекту по расшифровке генома человека, ученые хотели удовлетворить исследовательский интерес.
Тогда амбициозная задача ученых – понять наконец, как изменения в микробиоме сказываются на здоровье человека, – так и не была решена, равно как и расшифровка генома человека не дала окончательных ответов на то, как функционируют гены.
Ответы еще предстоит получить, и можно предположить, что они не будут однозначными.
Однако академические идеи были выхвачены из контекста и из-под чутких рук ученых, вынесены за пределы лабораторий и стали достоянием широкой публики, породив множество мифов и неверных интерпретаций.
То, что мы наносим на кожу «хорошие» бактерии и надеемся с их помощью победить «вредные» или принимаем внутрь препараты и считаем, что они безобидны, может тем не менее колебать баланс микроорганизмов. Вот почему очень важно прислушиваться к своему врачу и использовать правильные продукты и ингредиенты и только тогда, когда это действительно необходимо.
Нет «плохих» или «хороших» бактерий, важен только баланс между ними. И его поддержание в наших руках.

